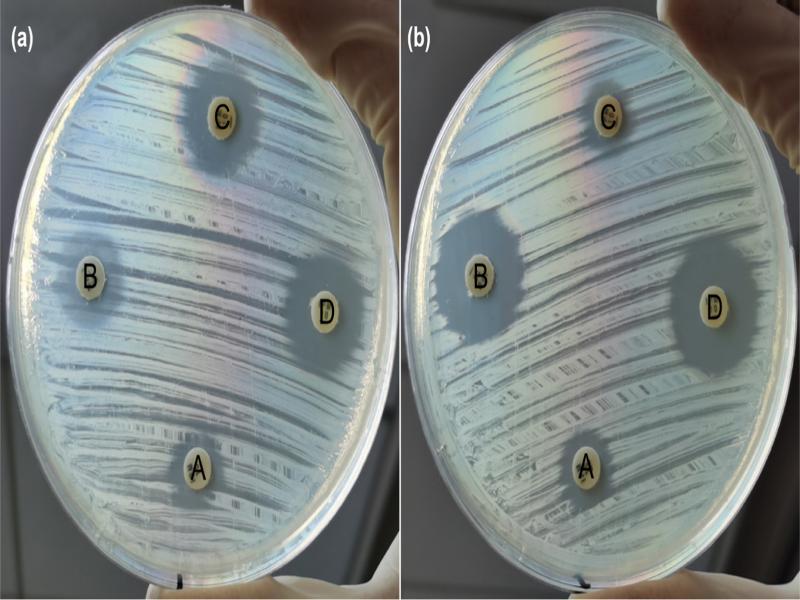

Infections caused by carbapenem-resistant Enterobacterales (CRE) are a major clinical challenge and a public health problem (WHO 2017). According to the 2019 report of the Centers for Disease Control and Prevention (CDC), CRE can cause 13,100 infections and 1,100 deaths per year in the USA (CDC 2019). The resistance to carbapenems in Enterobacterales is mainly associated with the production of different classes of carbapenemases (Nordmann et al. 2012).
Horizontal transfer of carbapenemase coding genes through mobile genetic elements such as plasmids and transposons between Gram-negative microorganisms is responsible for the rapid increase of carbapenemase-producing CRE (CP-CRE) isolates. Carbapenemases can hydrolyze not only carbapenems but also most other β-lactam antibiotics. There is often coexistence of additional resistance mechanisms to other antibiotic classes (e.g., fluoroquinolones and aminoglycosides) in CP-CRE isolates (van Duin and Doi 2017). It leads to very few treatment options available against these organisms (Nordmann et al. 2012; van Duin and Doi 2017). However, a few newly commercialized antibiotics (e.g., ceftazidime/avibactam and meropenem/vaborbactam) have been used for the treatment of Klebsiella pneumoniae carbapenemase (KPC) producers recently, but failed to treat metallo-β-lactamase (MBL) producers (King et al. 2017; Bassetti et al. 2018; Pfaller et al. 2018). Therefore, it is crucial to detect and differentiate KPC and MBL carbapenemase-producers rapidly in individual patients.
Several carbapenemase detection methods have been developed, including carbapenem hydrolysis derived methods, such as the modified Hodge test (Carvalhaes et al. 2010), modified carbapenem inactivation method (mCIM) (Pierce et al. 2017), Carba NP test (Laolerd et al. 2018), matrix-assisted laser desorption ionization-time of flight (MALDI-TOF) mass spectrometry assay (Papagiannitsis et al. 2015), carbapenemase activity inhibition based methods (Li et al. 2019), and antibody- (Kieffer et al. 2019) and PCR-based methods (Cointe et al. 2019). However, modified Hodge test, mCIM, Carba NP test, and MALDI-TOF assays cannot differentiate KPC and MBL carbapenemase, although the latter two methods require only about two hours to diagnose (Papagiannitsis et al. 2015; Pierce et al. 2017; Laolerd et al. 2018). Although antibody- and PCR-based methods can differentiate KPC and MBL within two hours, they cannot distinguish CRE from carbapenem-susceptible Enterobacterales (CSE) isolates when encountering an Enterobacterales isolate whose antimicrobial susceptibility is unknown. Besides, they are more expensive than other methods (Cointe et al. 2019; Kieffer et al. 2019). As a result, all of these available methods cannot meet the clinical requirements satisfactorily.
KPC and MBL are the most frequently encountered carbapenemases among CP-CRE isolates in China, and the latter is distributed worldwide (Logan and Weinstein 2017). Therefore, in the context, we explored a cheap, rapid, and accurate method to detect and characterize KPC and MBL carbapenemases among Enterobacterales isolates and to discriminate CRE from CSE for providing the basis of choice of antibiotics for clinicians to treat CP-CRE infected patients and prevent their further spread in medical institutions.
Bacterial isolates. A total of 253 retrospectively collected between January 2014 and January 2019, non-duplicate Enterobacterales isolates, including 163 CRE isolates and 90 third-generation cephalosporin-resistant Enterobacterales (3GCeRE) isolates from the Department of Infectious Diseases and Clinical Microbiology, Beijing Chao-Yang Hospital were included. CRE was defined as an isolate non-susceptible to imipenem or meropenem (for the bacteria intrinsically resistant to imipenem, non-susceptible to meropenem other than imipenem is required), with a minimum inhibitory concentration (MIC) ≥ 2 µg/ml, or producing carbapenemase. 3GCeRE was defined as an isolate resistant to ceftazidime (MIC ≥ 16 µg/ml), ceftriaxone (MIC ≥ 4 µg/ml), and cefotaxime (MIC ≥ 4 µg/ml), but susceptible to carbapenems. The MICs were measured by the broth microdilution (BMD) method, and the interpretative criteria were based on the Clinical and Laboratory Standards Institute (CLSI 2019). All the isolates were identified by the Vitek MALDI-TOF MS (bioMérieux, France).
Molecular detection of carbapenemase genes. As previously described, the blaIMP, blaNDM, and blaVIM genes were each detected by PCR (Jing et al. 2018). The blaNMC, blaSME, blaIMI, blaGES, blaSPM, blaGIM, blaSIM, and blaOXA-48-like genes were detected by a single primer set (Queenan and Bush 2007). The primers for the blaKPC gene used in the study were previously described (Poirel et al. 2011), but the PCR was performed by a different procedure. Briefly, 12.5 µl of PCR Master Mix (Thermo Scientific, USA) was mixed with 2 µl of forward and reverse primers and water to a final volume of 23 µl. Then, 2 µl of purified DNA template was added to the mix. The PCR program consisted of an initial denaturation step at 95°C for 5 min, followed by 35 cycles of denaturation at 95°C for 30 s, annealing at 55°C for 30 s, elongation at 72°C for 60 s, and a final extension at 72°C for 7 min. All of the primers used in the study are listed in Table SI.
The PCR products were sequenced bi-directionally using an ABI 3730XL DNA sequencer (Applied Biosystems, USA). The gene sequences were compared with those in the database located at the NCBI blast server (http://blast.ncbi.nlm.nih.gov). A minimum of 99% sequence identity and 99% coverage threshold was deemed to confirm each gene.
Phenotypic detection of KPC and MBL by a modified combined disk test. Inhibitor solutions of 50 mg/ml APB (3-aminophenyl boronic acid hydrochloride, Sigma-Aldrich, USA), and 0.5 M EDTA (ethylenediaminetetraacetic acid disodium salt dihydrate, Sigma-Aldrich, USA) were filtered using a 0.22 µm filter membrane (Millipore, Germany), and stored at 4°C (Petropoulou et al. 2006; Doi et al. 2008). The modified combined disk test (mCDT) was carried out using four 10-μg imipenem (or meropenem) disks (Oxoid, UK), including a disk alone, a disk plus 5 µl (or 10 µl) of APB for KPC inhibition, a disk plus 5 µl (or 10 µl) of EDTA for MBL inhibition, and a disk plus both APB and EDTA for simultaneous inhibition of KPC and MBL (Tsakris et al. 2010; Pournaras et al. 2013). The four disks were placed onto Mueller-Hinton agar (Becton, Dickinson and Company, USA) plates inoculated with bacterial suspensions of 2.80 ± 0.15 McFarland optical density. The inhibition zones were measured after incubation for 6 hours at 35 ± 2°C in ambient air. An increase of ≥ 5 mm in the inhibition zone diameter of the imipenem (or meropenem) disk containing inhibitors (APB, EDTA, or both) in comparison to the same disk without the corresponding inhibitor was suggestive of KPC, MBL, or both carbapenemases production, respectively. Quality control strains included Escherichia coli ATCC 25922, Klebsiella pneumoniae ATCC BAA-1705, and Klebsiella pneumoniae ATCC BAA-1706.
Statistical analysis. The sensitivity and specificity were determined to assess the performance of mCDT for the identification and differentiation of carbapenemase using PCR results as a standard. Data were analyzed using the VassarStats online software (VassarStats.net).
Species distribution and carbapenemase genes. One hundred and sixty-three CRE and ninety 3GCeRE isolates comprised eight bacterial species: K. pneumoniae (n = 141), E. coli (68), Klebsiella aerogenes (n = 14), Enterobacter cloacae (n = 13), Proteus mirabilis (n = 5), Providencia rettgeri (n = 5), Citrobacter freundii (n = 4), and Serratia marcescens (n = 3). The PCR and sequencing results are shown in Table I. One hundred and forty-five CRE isolates were confirmed to be carrying carbapenemase genes. Of them, the blaKPC gene was the most often discovered carbapenemase gene (n = 107), followed by the blaNDM gene in 30 isolates, blaIMP in six isolates, and blaOXA-48-like in one isolate, as well as both blaKPC and blaNDM in one isolate. The remaining 18 CRE isolates and all 3GCeRE isolates were negative for carbapenemase genes.
Species distribution of different carbapenemase types among non-CP-CRE and 3GCeRE isolates.
| Category (n) | Species | |||||||
|---|---|---|---|---|---|---|---|---|
| Kpn | Eco | Ecl | Kae | Cfr | Pre | Pmi | Sma | |
| KPC (107) | 104 | 1 | 0 | 1 | 1 | 0 | 0 | 0 |
| MBL (36) | ||||||||
| NDM (30) | 7 | 15 | 1 | 0 | 1 | 4 | 1 | 1 |
| IMP (6) | 3 | 0 | 3 | 0 | 0 | 0 | 0 | 0 |
| OXA-48-like (1) | 1 | 0 | 0 | 0 | 0 | 0 | 0 | 0 |
| KPC+NDM (1) | 1 | 0 | 0 | 0 | 0 | 0 | 0 | 0 |
| Non-CP-CRE (18) | 8 | 5 | 2 | 3 | 0 | 0 | 0 | 0 |
| 3GCeRE (90) | 17 | 47 | 7 | 10 | 2 | 1 | 4 | 2 |
| Total (253) | 141 | 68 | 13 | 14 | 4 | 5 | 5 | 3 |
Kpn – Klebsiella pneumoniae, Eco – Escherichia coli, Ecl – Enterobacter cloacae, Kae – Klebsiella aerogenes,
Cfr – Citrobacter freundii, Pre – Providencia rettgeri, Pmi – Proteus mirabilis, Sma – Serratia marcescens
Differentiation of CRE and 3GCeRE isolates. The distribution of inhibitory zone diameter (IZD) of the imipenem disk alone after six hours of incubation is shown in Fig. 1a. The IZDs of all CRE isolates were ≤ 18 mm, while all 3GCeRE isolates were ≥ 19 mm. For three P. mirabilis the value of IZD was the same and equal to 18 mm. Therefore, apart from the three P. mirabilis isolates, the imipenem disk alone could distinguish CRE from all the other 3GCeRE isolates after six hours of incubation.
Fig. 1.
The inhibitory zone diameter distribution of a) imipenem, b) meropenem for Enterobacterales isolates tested.

Compared with imipenem, the distribution of IZDs of meropenem disk alone provided a clear distinction of CRE and 3GCeRE isolates (Fig. 1b). The IZDs of all CRE isolates were ≤ 18 mm, while all 3GCeRE isolates were ≥ 20 mm.
Sensitivity and specificity of mCDT. The interpretation of the mCDT results is shown in Fig. 2. When the IZD value of imipenem or meropenem disk alone was ≥ 19 mm, the Enterobacterales isolate was deemed CSE, otherwise deemed CRE. Subsequently, an increase of ≥ 5 mm in the IZD of the imipenem (or meropenem) disk containing inhibitors (APB, EDTA, or both) compared to the disk without the corresponding inhibitor is deemed as KPC among CRE isolates, MBL, or both carbapenemases producer, respectively. At the same time, an increase of < 5 mm was deemed as OXA-48-like carbapenemase or non-CP-CRE isolate. Fig. 3 shows examples of mCDT results.
Fig. 2.
Flow diagram of the mCDT for distinguishing CRE from CSE isolates, and differentiating KPC and/or MBL producers.
A – imipenem disk alone, B – imipenem disk plus 5 µl EDTA, C – imipenem disk plus 10 µl APB and D – imipenem disk plus 5 µl EDTA and 10 µl APB.

Fig. 3.
Examples of mCDT showing the inhibitory zone diameters of A, B, C, and D for a) a plate 7, 7, 14, and 15 mm confirming the KPC-producing isolate, and for b) a plate 9, 17, 8, 18 mm confirming the MBL-producing isolate.
A – imipenem disk alone, B – imipenem disk plus 5 µl EDTA, C – imipenem disk plus 10 µl APB and D – imipenem disk plus 5 µl EDTA and 10 µl APB.
The accuracies of the mCDT among CRE isolates are shown in %Table II. For identification of KPC carbapenemase, the sensitivity of the IPM (imipenem)-5 µl APB was 88.8% (95/107), with a specificity of 100% (56/56). One C. freundii and 11 K. pneumoniae isolates were a false negative. Three K. pneumoniae isolates were incorrectly identified as non-CP-CRE or OXA-48-like producers, while the remaining eight isolates were incorrectly identified as KPC and MBL producers. The sensitivity of the IPM-10 µl APB was 97.2% (104/107), with a specificity of 100% (56/56). Three K. pneumoniae isolates were incorrectly identified as both KPC and MBL producers. These three organisms gave similar results with IPM-5 µl APB group. However, the sensitivities of the MEM (meropenem)-5 µl APB and MEM-10 µl APB were 48.6% (52/107) and 59.8% (64/107), respectively, with specificities of 100% (56/56) in both groups. Tiny bacterial colonies were observed for many KPC-producing isolates around MEM disk with APB. Therefore, the sensitivities for MEM-5 µl APB and MEM-10 µl APB groups were much lower than that of IPM with APB groups. Fifty and 36 isolates were incorrectly identified as non-CP-CRE or OXA-48-like producers, while five and seven isolates were incorrectly identified as both KPC and MBL producers in MEM-5 µl APB and MEM-10 µl APB group respectively.
Accuracy of detecting KPC or MBL carbapenemases among 163 CRE isolates under different conditions.
| Category | Carbapenemase | Accuracy | |
|---|---|---|---|
| Sensitivity (%), (95% CI) | Specificity (%), (95% CI) | ||
| IPM-5 μ APB | KPC | 88.8 (80.9-93.8) | 100 (92.0-100) |
| IPM-5 μ EDTA | MBL | 100 (88.0-100) | 100 (96.3-100) |
| IPM-10 μ APB | KPC | 97.2 (91.4-99.3) | 100 (92.0-100) |
| IPM-10 μ EDTA | MBL | 100 (88.0-100) | 100 (96.3-100) |
| MEM-5 μ APB | KPC | 48.6 (38.9-58.4) | 100 (92.0-100) |
| MEM-5 μ EDTA | MBL | 100 (88.0-100) | 100 (96.3-100) |
| MEM-10 μ APB | KPC | 59.8 (49.9-69.0) | 100 (92.0-100) |
| MEM-10 μ EDTA | MBL | 100 (88.0-100) | 100 (96.3-100) |
IPM – imipenem, MEM – meropenem, APB – 3-aminophenyl boronic acid hydrochloride,
EDTA – ethylenediaminetetraacetic acid disodium salt dihydrate
For the identification of MBL carbapenemases, the sensitivity of the IPM-5 µl EDTA was 100% (36/36), with a specificity of 100% (127/127). The same results were obtained for IPM-10 µl EDTA, MEM-5 µl EDTA, and MEM-10 µl EDTA groups.
No statistical analysis was performed for this type because there was only one isolate that produced both KPC and NDM carbapenemases. The isolate was correctly identified for all IPM or MEM disks with APB + EDTA groups.
The current study detected five different genes by PCR and sequencing method in 88.9% of CRE isolates (n = 163). The results showed that the blaKPC (73.8%) and blaNDM (20.7%) genes were most common, followed by blaIMP (4.1%), blaOXA-48-like (0.7%), and blaKPC+NDM (0.7%). It follows a report of nationwide surveillance of clinical CRE isolates in China, which showed 93% of clinical isolates (n = 1105) producing carbapenemases, with a majority of isolates producing KPC (57%) or NDM (31%) carbapenemases (Zhang et al. 2017). Therefore, the main carbapenem-resistant mechanism for clinical Enterobacterales isolates is acquiring the blaKPC or blaNDM genes in China.
Due to the high morbidity and mortality associated with the invasive infection of CP-CRE strains (CDC 2019), accurate and fast detection and differentiation of CP-CRE types are critical in the individual patient. It will help the physicians make decisions on appropriate antibiotic treatment and improve prevention and control, especially in outbreak situations (Gutiérrez-Gutiérrez et al. 2017; Livermore et al. 2018; Li et al. 2019). Although several methods have been proposed (Burckhardt and Zimmermann 2011; Findlay et al. 2015; Bogaerts et al. 2020) they cannot fully meet the clinical demands. The mCIM plus EDTA-carbapenem inactivation method (eCIM) and CDT require more than 20 hours. Besides, mCIM/eCIM could not detect MBL carbapenemase when an Enterobacterales isolate produced two types of carbapenemases, including the MBL carbapenemase (Tsai et al. 2020). While Carba NP and MALDI-TOF MS are rapid, it cannot differentiate the type of a carbapenemase. In addition, commercial immunochromatographic assay and PCR method require high cost and cannot distinguish CRE from CSE.
In recent years, a simplified carbapenem inactivation method (sCIM) for detecting carbapenemases with high accuracy has been established (Jing et al. 2018; Yamada et al. 2021). Compared to mCIM, it is easier to carry out by smearing the test strain onto an imipenem/meropenem disk and then placed the disk on Mueller-Hinton agar streaked with 0.5 McFarland standard Escherichia coli ATCC 25922. The result was read after overnight incubation. However, similar to mCIM, the long incubation time and inability to distinguish the type of carbapenemases will limit its widespread use in clinical practice.
This study developed the mCDT method because APB can inhibit the KPC carbapenemase and EDTA can inhibit MBL carbapenemases (Petropoulou et al. 2006; Doi et al. 2008). A higher initial concentration of the bacteria tested will reduce the time to form visible bacterial colonies. However, when the initial bacterial suspension was set for 3.5 McFarland optical density, the inhibitory effect of APB on the KPC carbapenemase was significantly reduced for many isolates, and tiny bacterial colonies could be seen around an imipenem disk with APB (Fig. S1). Thus, the inoculum was 2.80 ± 0.15 McFarland optical density (less than 3) to prevent the tiny bacterial colonies in this study. The incubation time was set for six hours, making it easy to read results due to the formation of a clear inhibition zone compared to five hours or less. Therefore, it is a facile and inexpensive in-house approach, which requires only six hours because the bacteria’s high concentration (2.80 ± 0.15 McFarland optical density) is inoculated.
The mCDT can be utilized to detect CRE in clinical laboratories and simultaneously differentiate the KPC and MBL type of CP-CRE isolates. An overnight pure culture of bacteria identified as Enterobacterales strains can be used for mCDT in the morning, and the result can be acquired after six hours of incubation in the afternoon. As a result, this method can shorten the turnaround time since it can be carried out simultaneously as the antibiotic susceptibility test and acquire the results in six hours. It should be noted that an IZD of 18 mm as the breakpoint we describe is smaller than the IZD of 22 mm for imipenem and meropenem proposed by CLSI to distinguishing CRE from CSE isolates (CLSI 2019). In this study, applying the 18 mm breakpoint could detect all CRE strains and exclude all 3GCeRE strains for meropenem disk, but the IZDs of imipenem disk for three carbapenem-susceptible P. mirabilis isolates were 18 mm due to the intrinsic imipenem resistance. It is observed for Morganella morganii, Proteus spp., and Providencia spp. (CDC 2019). Therefore, it is better to use a meropenem disk to distinguish CRE from CSE isolates for those intrinsically imipenem-resistant strains.
APB inhibits KPC carbapenemase due to the boronate moiety binding to the catalytic serine side chain; thus, forming the covalent adduct and inactivating it (Hecker et al. 2015). In the current study, most KPC-producing isolates could not be detected by meropenem but imipenem disk due to tiny bacterial colonies formed around a meropenem disk with APB. This result indicates that the covalent adduct still retains a low level of catalytic efficiency, and the catalytic efficiency to meropenem is higher than that of imipenem. The reason may be that the affinity of the covalent adduct to meropenem is higher than that of imipenem.
This study has some limitations. First, the mCDT was not suitable for detecting OXA-48-like carbapenemases because there is no specific inhibitor against OXA-48-like carbapenemases available. Second, this study did not include MBL carbapenemases except NDM and IMP (e.g. VIM and others). Third, this method cannot detect class A carbapenemases except KPC (e.g. GES, SME) because they cannot be inhibited by APB (Nordmann et al. 2012). According to the report of Lee and Suh (2021), detection of GES by modified Hodge test (MHT), mCIM, and Rapidec Carba NP was also very poor, which is a tricky problem.
In summary, the proposed mCDT that used 10 μl APB and 5 μl EDTA as inhibitors enables detection and differentiation of KPC and MBL carbapenemase types and distinguishes CRE from CSE simultaneously within six hours among Enterobacterales isolates. It could be a low cost, high accuracy, and easy operational approach. While this approach requires validation in other laboratories, we believe that the mCDT may be useful, especially in low-income countries and regions where KPC and MBL carbapenemases are epidemics.